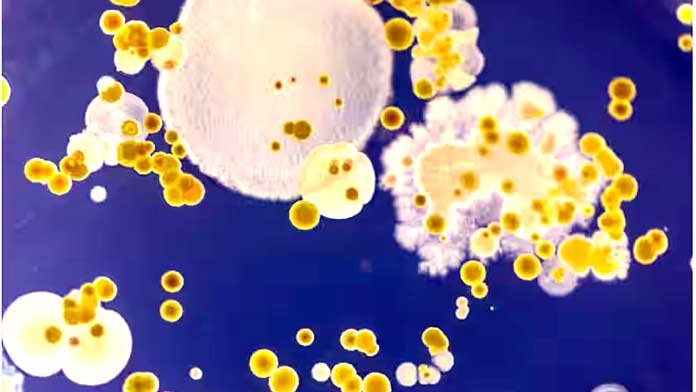
featured

Three-times F1 World Champ title winner Niki Lauda blasted the British driver, as “boring”, claiming modern drivers have “no idea”. The 59-year-old, world title winner of 1975, 1977 and 1984, said: “The only kind of charisma someone like Lewis Hamilton has is h is girl Nicole Scherzinger.”
“When I was racing, everyone was ready to drive over someone else to win. Death was always an option. Today’s drivers have no idea,” the Daily Star quoted Lauda, as saying. However, the Current F1 champ Hamilton himself has admitted that he is “boring” on a night out.
The 24-year-old on course to become Britain’s first sports billionaire said recently: “I’m a boring bar person because if I am out I will only have a Coke or orange juice.” Lauda, who was fighting for life after a racing crash in 1976, is well known for his criticism about current Formula 1 drivers.
Earlier, Lauda had said that Lewis Hamilton was robbed of victory in the Belgian Grand Prix, and described the penalty as “the worst judgment in the history of F1. He had said the sport was close to losing its integrity after Hamilton had been hit with a retrospective 25-second drive-through penalty for `cutting a corner and gaining an advantage’.
“So I do not understand this decision, and it’s really bad for the sport because people watching will not watch any more because of this stupid decision,” Lauda said.
RELATED POSTS
View all